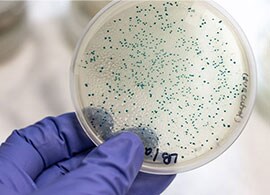
Model organism E. coli A scientist’s gloved hand holding a petri dish with hundreds of distinct E. coli colonies

Search
Search
Bacterial transformation is a natural process where cells take up foreign DNA from the environment. After transformation, the cells may express the new genetic information, which can serve as a source of genetic diversity and offer advantages like antibiotic resistance. However, natural bacterial transformation occurs at a low frequency, 10-2–10-10, and highly variable between bacteria species [1,2]. With the advent of molecular cloning in the 1970s, the process of transformation was leveraged to introduce recombinant plasmid DNA into bacteria in vitro. These bacteria, known as competent cells, are specially engineered strains designed to easily uptake and maintain foreign DNA.
Cell competence refers to the ability of a cell to take up exogenous DNA. The natural competency or transformability of bacteria was first reported by Griffith in 1928 [3]. He noted that mice died when injected with the virulent “smooth” pneumococcus (Streptococcus pneumoniae) but did not die from the nonvirulent “rough” strain. The presence of a polysaccharide coating imparts a smooth appearance to pneumococcus and prevents recognition of the bacterial cells by the host’s immune system. Heat killing eliminated the virulence of the smooth strain. However, when the heat-killed smooth strain was mixed with the nonvirulent rough strain, the rough strain acquired the smooth phenotype and was virulent (Figure 1). Griffith’s experiments suggested that a non-living, heat-stable material derived from the smooth strain was responsible for the transformation. In 1944, Avery et al. identified the transformative agent as DNA [4].
Figure 1. The Griffith experiments. By injecting mice with either the smooth (virulent) or rough (nonvirulent) pneumococcus, heat killing, and observing survival, Griffith’s experiment suggested that transformation is dependent on the non-living, heat-stable material derived from the smooth strain, which would later be identified as DNA.
In 1970, Mandel and Higa published the first protocol for artificial transformation of E. coli [5]. It is the deliberate and controlled process of introducing foreign DNA into bacterial cells in a laboratory setting. The procedure demonstrated how treating bacterial cells with calcium ions (Ca2+) and brief exposure to an elevated temperature, known as heat shock, could increase cell permeability (Figure 2). This method forms the basis for chemical transformation. In 1983, Hanahan published an improvised method to prepare competent cells, in which optimal conditions and media for bacterial growth and transformation were identified to achieve higher transformation efficiency [6].
An alternate to chemical transformation is electroporation, which involves application of an electrical field to enhance uptake of DNA in cells. In 1982, Neumann et al. reported introduction of foreign DNA into mouse cells by applying short pulses of high-voltage electric fields [7]. These electric fields increase the cell’s membrane potential, thereby inducing transient permeability to charged molecules like DNA. In 1988, E. coli transformation by electroporation was reported [8]. Figure 2 illustrates inducing cell competence through both chemical methods and electroporation.
Great strides have been made in developing many strains of competent cells tailored for various applications, and E. coli-derived competent cells are most popular among researchers.
Figure 2. Chemical transformation and electroporation workflow.
Today, E. coli is the best understood organism on the planet [9]. It has been instrumental in many fundamental discoveries, such as elucidation of genetic code, DNA replication, transcription, gene regulation, and many more. It serves as mini bioreactors for synthesizing life changing pharmaceuticals to treat deadly diseases; for example, recombinant insulin to treat diabetes. Even today, E. coli continue to have a significant role in advancing science.
E. coli was first discovered by a German microbiologist and pediatrician Theodor Escherich while studying infant gut microbes in 1884. First, it was known as Bacterium coli commune and later renamed to Escherichia coli to honor the scientist who discovered it. The adaptation as a model organism stems from the ease to isolate and grow it in laboratory conditions; it requires a simple growth medium and has a rapid growth rate—doubling every hour. Most importantly, it is non-pathogenic making it widely accessible in laboratory collections, thereby it became a first choice in early microbiological studies.
E. coli belongs to the family of Gram-negative bacilli Enterobacteriaceae and is related to pathogens such as Salmonella and Klebsiella. It is a rod-shaped bacterium measuring 1 μm long by 0.35 μm wide and may have flagella for movement or pili for attachment to surfaces. E. coli is a mesophilic bacterium reported to grow in 21°C to 49°C temperature range, with 37°C being optimum, although some strains can grow at much lower temperatures.
Wild-type E. coli strains share less than 20% of core genes demonstrating a great genome plasticity. Popular K-12 laboratory strain has a genome of around 4.6 million base pairs with about 4,300 genes of which around 300 genes are essential [10,11].
The wild-type E. coli K-12 stain was isolated from a diphtheria patient in 1922 at Stanford University. Subcultures of this strain were first reported in 1944 and since then many laboratory strain derivatives have been engineered using multiple genetic methods. WG1 and EMG2 (wild-type K-12 strains) are progenitors of many key laboratory strains [12]. By 1981, a common laboratory strain MG1655 had been developed by Guyer et al. Currently, most widely used K-12 strains designated DH (DH5α, DH10B, and other derivatives) were engineered by Hanahan and team by replacing alleles using P1 transductions (MC1061 was chosen as starting strain) [13]. Genetically, DH strains are closely related to MG1655, albeit, with extensive genetic manipulations (>200 mutated genes) [13]. DH strains have several properties that made them ideal for cloning applications, these include:
E. coli strain BL21 is one of the most widely used hosts for high-level recombinant protein production. The lack of lon and ompT proteases was the main driver for BL21 strain adaptation. Further, BL21 (DE3) strain was created by Studier and Moffatt and published in 1986. It carries the T7 RNA polymerase gene under the control of the lacUV5 promoter for inducible high level recombinant protein expression thus becoming one of most widely used B stain today [14].
B strain ancestry had been traced back to a strain from the Institut Pasteur in Paris used by d'Herelle in his studies of bacteriophages as early as 1918. This strain passed via multiple laboratories and finally ended in Luria’s hands in 1941. In 1942, Delbrück and Luria published the first paper identifying the B strain [15]. Later, B strains had been used as a common host for T1–T7 phages by many research groups including Bordet and Wollman. Further genetic manipulations to the B strain led to development of BL21 as we know it today. BL21 origins and lineage has been traced back through genome sequences.
Bacteriophages, the natural bacteria killers, are the most abundant life form on the planet. These bacterial viruses are very simple: compact genomes comprised form either DNA or RNA and encapsulated by a protein coat with a tail which has fibers to attach on bacterial cell surface. Phage genome size varies enormously coding from a few genes to several hundred genes. After infection, bacteriophages can propagate in two ways:
In 1952, Zinder and Lederberg reported a process called transduction, where phages could package bacterial DNA (chromosomal or plasmid) and carry it to another bacterium host. Phages are the most effective gene-transfer particles in the nature, enabling bacteria to acquire genes for rapid adaption to changing environments [17].
Infection of laboratory E. coli cultures by bacteriophages are a serious challenge in both research and biotechnology laboratories. The most common phage contaminants are T1-like phages, T5-like, and others (T4-like, M13-like, and P1-like families among others). Prevention strategies are necessary to avoid phage contamination; despite best efforts, phage contamination occurs from time to time. To help battle this issue, it is recommended to use E. coli strains, which bear tonA, also known as fhuA mutation, that confers resistance to T1, T5, and φ80 phages.
Phage display is a molecular technique introduced in 1985 and used for discovery of polypeptides. Filamentous E. coli phages such as M13, lambda, or T7 are employed in this method. DNA encoding polypeptides is fused with gene encoding phage coat protein that are expressed on the surface. Phage display libraries are created to screen and identify polypeptide sequences that demonstrate high binding affinity to target. Later, they can be used in designing novel drugs, understanding protein-protein interactions, or serve as mimics to block receptors.
Transformation is the mechanism by which DNA is taken by bacterial cell from the environment. This phenomenon occurs in nature between bacteria under specific environmental conditions at low efficiency. Competency can be artificially introduced (chemically or by electroporation) to enable target DNA to be taken by E. coli.
Transfection is a technique used to insert foreign nucleic acids into eukaryotic cells. It can be classified into two types: stable or transient. Transient transfection does not require nucleic acid integration into host cell genome thus the transgene will be lost during replication. To achieve stable transfection, genetic material needs to be integrated into a host cell genome. This can be achieved using a viral or plasmid vector that includes the presence of a suitable eukaryotic promoter.
Since the development of artificial transformation of E. coli by chemicals and electroporation, preparations of competent cells, as well as other methods of transformation, are continually being devised to improve uptake of DNA [18–21]. In 1984, Gibco BRL (now part of Thermo Fisher Scientific) became the first company to offer competent cells commercially by introducing HB101 and RR1 (recA+ version of HB101) strains. In the late 80s, Thermo Fisher Scientific acquired an exclusive license to commercialize and distribute original DH strains from Hanahan laboratory. Since then, we ensure that the scientific community has the access to seminal, unchanged stocks of popular strains as DH5α and DH10B.
Today, a variety of premade competent cell for different transformation methods, transformation efficiencies, genotypes, and packaging are available in ready-to-use formats from Thermo Fisher Scientific. These competent cells are quality-controlled and tested to meet specifications for transformation efficiency and genotypes.
Have any questions on competent cells or transformation? Click on the resources listed below to access overviews, videos, genotype guides, and educational resources.
Review rich educational content on transformation workflow, troubleshooting, strategies, and selection guides.
Stay up-to-date on industry trends in molecular cloning with on-demand webinars.
Access white papers and technical and application notes on molecular cloning.
Watch instructional videos on troubleshooting tips, how-to videos, and explainers related to molecular cloning.